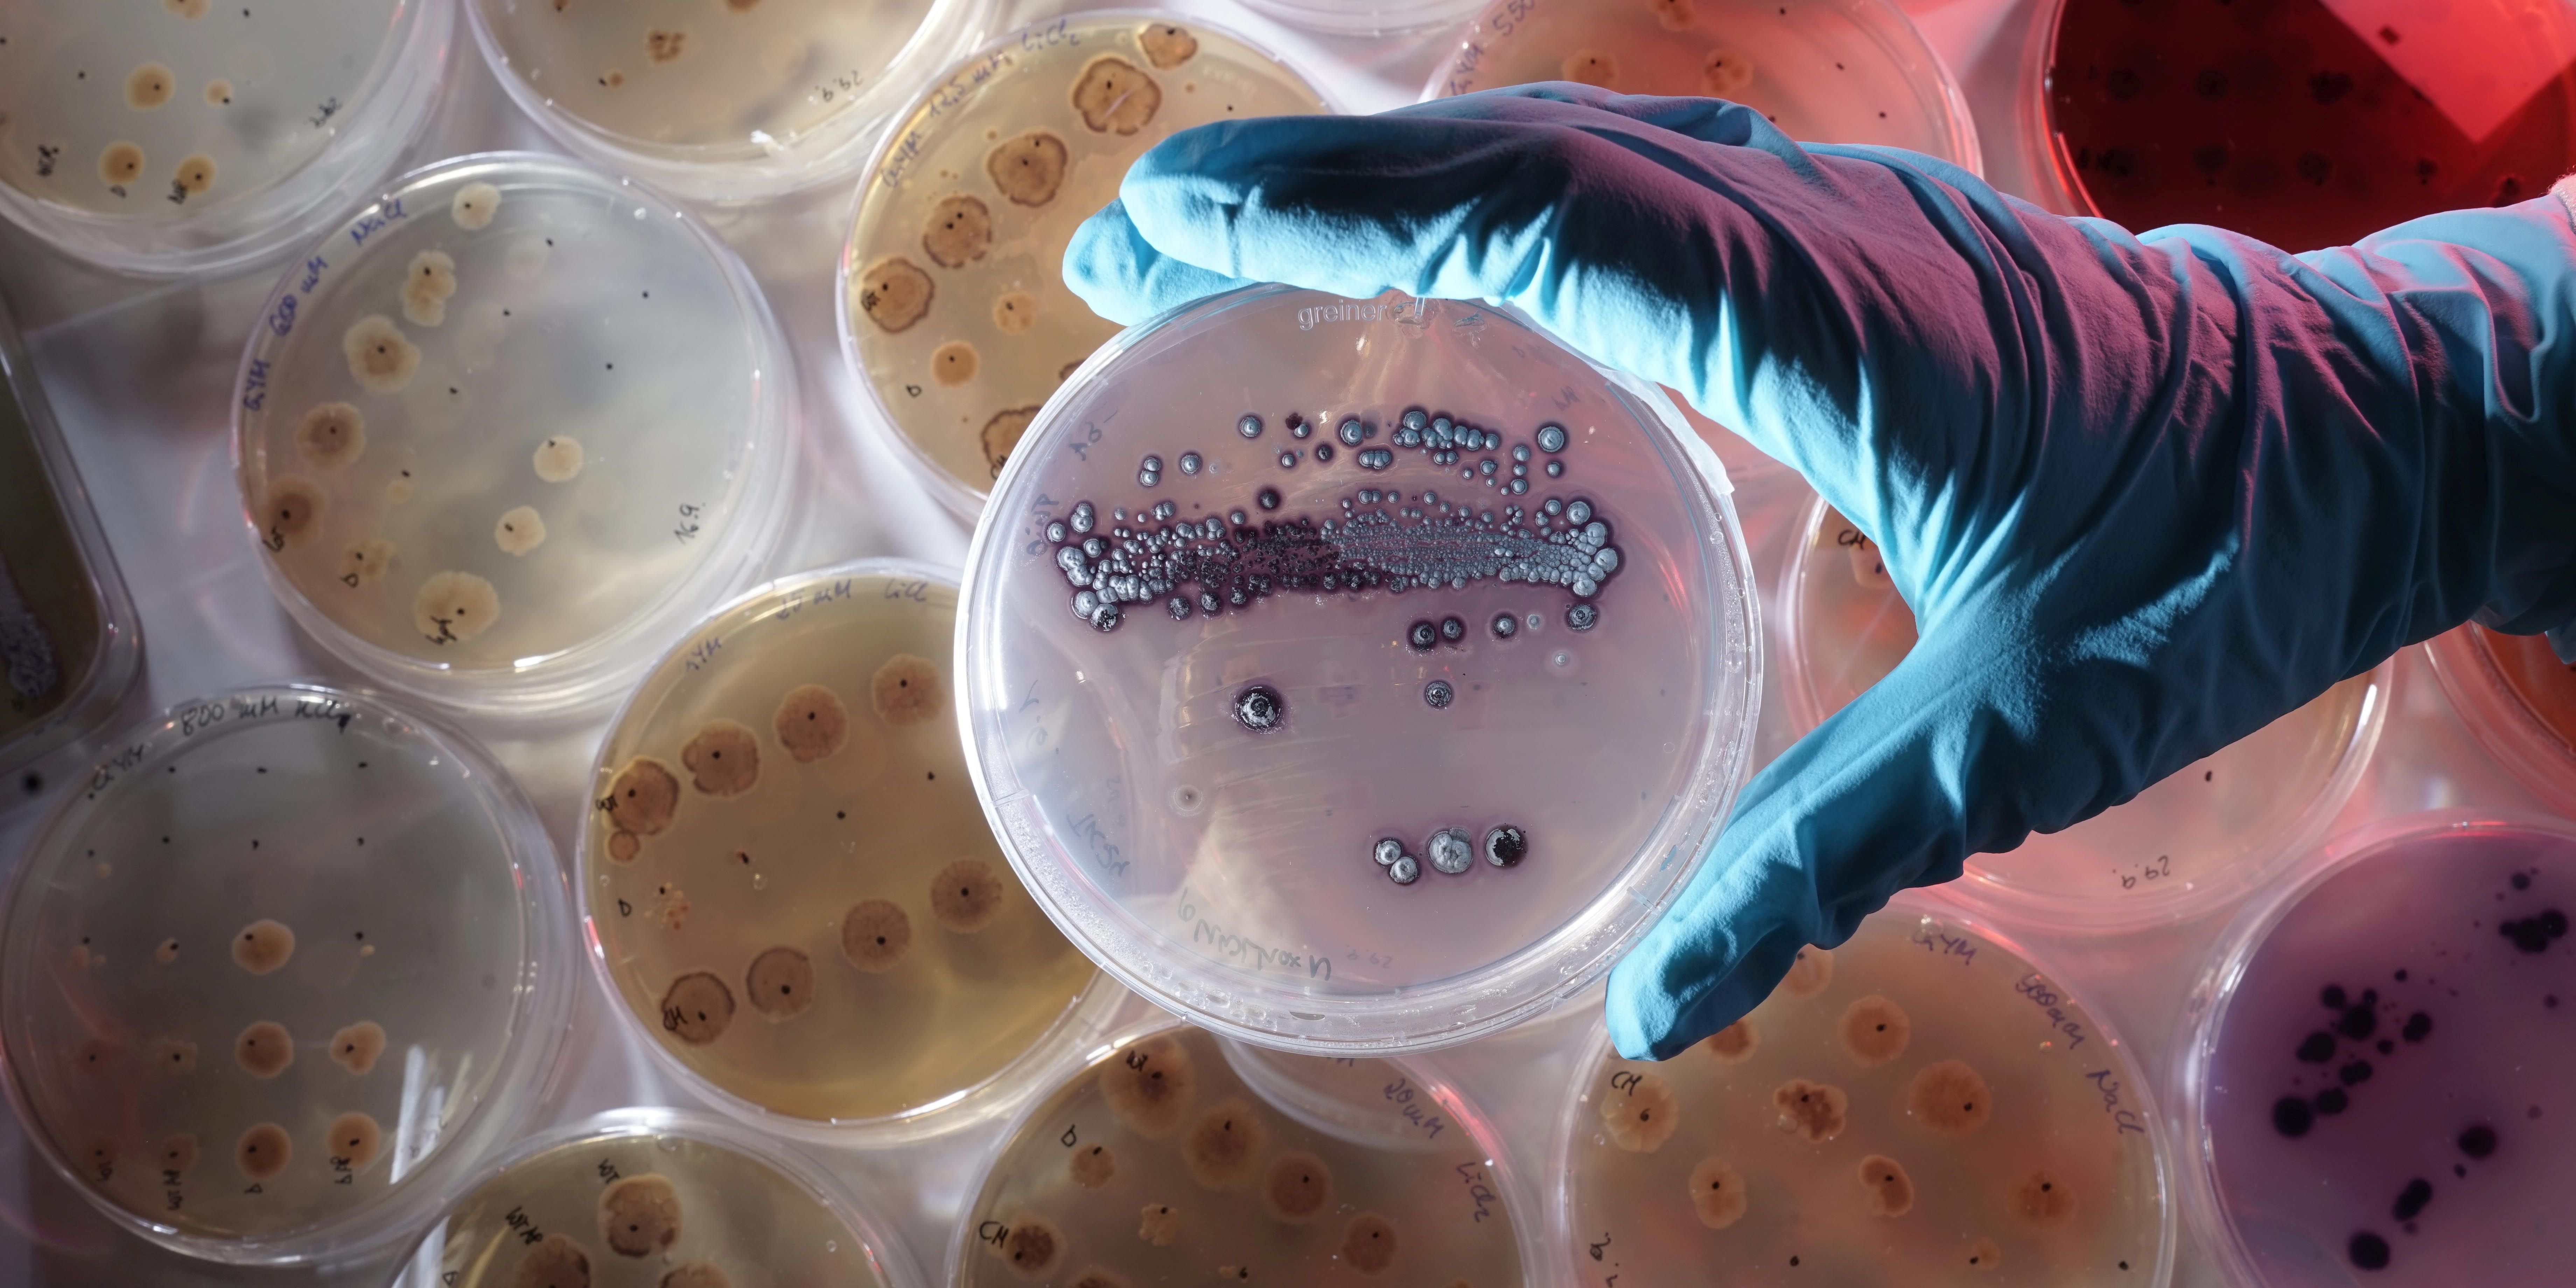
Forschungsprojekt zur Bodensanierung bei Ronneburg

Forschungsprojekt zur Bodensanierung bei Ronneburg
Mit fast einer Million Euro fördert das Bundesforschungsministerium ein Langzeitprojekt der Universität Jena. Dabei sollen biologische Methoden erforscht und getestet werden, um belastete Böden des ehemaligen Uranbergbaureviers Ronneburg bei Gera zu sanieren. Die Mikrobiologin Prof. Dr. Erika Kothe leitet das jetzt gestartete Projekt gemeinsam mit dem Geowissenschaftler Prof. Dr. Thorsten Schäfer. Vier Testfelder werden untersucht. Bereits seit vier Jahren erforschen Gruppen aus den Bio- und Geowissenschaften dort sanfte und bioverträgliche Methoden für eine langfristige Nutzung der Flächen – insbesondere die Möglichkeiten, dort Biomasse zu produzieren. Das Nachfolgeprojekt knüpft an die Erfolge der ersten Förderphase an: Auf einem Testfeld setzten die Forschungsteams Bäume ein, die trotz der Belastung wuchsen und als Energielieferant dienen. cd/Foto: Jan-Peter Kasper/FSU





















Überwiegend bewölkt